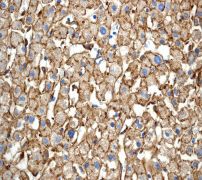

> Antigen, Antibodies, ELISA, Western Blot > Primary Antibody > Monoclonal Antibodies > LRP1 AntibodyBrand |
Leading Biology | Catalog Number |
APR07037G |
Product Type |
Monoclonal Antibodies | Field of Research |
|
Product Overview |
We constantly strive to ensure we provide our customers with the best antibodies. As a result of this work we offer this antibody in purified format.
We are in the process of updating our datasheets. If you have any questions regarding this update, please feel free to contact our technical support team.
This product is a high quality LRP1 antibody.
|
||
Molecular Weight |
504606 Da
|
||
Cellular Localization |
Antigen Cellular Localization:
Low-density lipoprotein receptor-related protein 1 85 kDa subunit: Cell membrane; Single-pass type I membrane protein. Membrane, coated pit Low-density lipoprotein receptor-related protein 1 intracellular domain: Cytoplasm. Nucleus. Note=After cleavage, the intracellular domain (LRPICD) is detected both in the cytoplasm and in the nucleus
|
||
Host |
Rabbit
|
||
Species Reactivity |
Human, Mouse, Rat
|
||
Target |
A synthetic peptide corresponding to residues in human LRP1 was used as an immunogen.
|
||
Clone |
EPR3724
|
||
Symbol |
A2MR, APR
|
||
GeneID |
|||
UniProt ID |
|||
Function |
Endocytic receptor involved in endocytosis and in phagocytosis of apoptotic cells. Required for early embryonic development. Involved in cellular lipid homeostasis. Involved in the plasma clearance of chylomicron remnants and activated LRPAP1 (alpha 2-macroglobulin), as well as the local metabolism of complexes between plasminogen activators and their endogenous inhibitors. May modulate cellular events, such as APP metabolism, kinase-dependent intracellular signaling, neuronal calcium signaling as well as neurotransmission.
|
||
Summary |
The LDL receptor-related protein (LRP1) is a large endocytic receptor that is widely expressed in several tissues. LRP1 is a member of the LDL receptor family that plays diverse roles in various biological processes including lipoprotein metabolism, degradation of proteases, activation of lysosomal enzymes, and cellular entry of bacterial toxins and viruses. LRP1 can recognize more than 30 distinct ligands, bind a large number of cytoplasmic adaptor proteins via determinants located on its cytoplasmic domain in a phosphorylation-specific manner, and can associate with and modulate the activity of other transmembrane receptors such as integrins and receptor tyrosine kinases (1). This multi-talented receptor has been implicated in regulation of platelet derived growth factor receptor activity, integrin maturation and recycling, and focal adhesion disassembly (2).
|
||
Form |
50 mM Tris-Glycine (pH 7.4), 0.15 M NaCl, 40% Glycerol, 0.01% sodium azide and 0.05% BSA. |
||
Storage & Stability |
Store at +4°C short term. For long-term storage, aliquot and store at -20°C or below. Stable for 12 months at -20°C. Avoid repeated freeze-thaw cycles.
|
||
Applications |
WB, IHC, IF
|
||
Dilution |
WB~~1:20000~50000
IHC~~1:100~250
|
||
Synonyms |
Prolow-density lipoprotein receptor-related protein 1, LRP-1, Alpha-2-macroglobulin receptor, A2MR, Apolipoprotein E receptor, APOER, CD91, Low-density lipoprotein receptor-related protein 1 85 kDa subunit, LRP-85, Low-density lipoprotein receptor-related protein 1 515 kDa subunit, LRP-515, Low-density lipoprotein receptor-related protein 1 intracellular domain, LRPICD, LRP1, A2MR, APR
|
||
Images |

Western blot analysis on (A) PMBC, (B) A549, (C) mouse brain, (D) mouse heart, (E) mouse kidney, (F) mouse spleen, (G) rat brain, (H) rat heart, (I) rat kidney and (J) rat spleen lysates using anti-LRP1 RabMAb (Cat. APR07037G).
Immunohistochemical analysis of paraffin-embedded human liver tissue using anti-LRP1 RabMAb. 
Immunofluorescent staining of HEPG2 cells using anti-LRP1 RabMAb (Cat. APR07037G). |
||
Specification |
|||
Quantity |
|
||
| Select | Brand | Catalog No. | Product Name | Pack Size | Type | Field of Research | Specification | Quantity | Price(USD) | |
| 1 | Leading Biology | APG02467G | CCK4 / PTK7 Antibody (clone 4F9) | 50 μl | Monoclonal Antibodies |
|
$495.00 | Add Ask | ||
| 2 | Leading Biology | AMM04683G | GALT Antibody (clone 4C11) | 50 μg | Monoclonal Antibodies |
|
$545.00 | Add Ask | ||
| 3 | Leading Biology | AMM01402G | Vimentin (Mesenchymal Cell Marker) Antibody - With BSA and Azide | 50 ug | Monoclonal Antibodies |
|
$395.00 | Add Ask | ||
| 4 | Leading Biology | APR08280G | LTA4H / LTA4 Antibody (clone 9G8) | 50 μl | Monoclonal Antibodies |
|
$495.00 | Add Ask | ||
| 5 | Leading Biology | AMM00172G | CD1a / HTA1 (Mature Langerhans Cells Marker) Antibody - With BSA and Azide | 50 ug | Monoclonal Antibodies |
|
$395.00 | Add Ask | ||
| 6 | Leading Biology | AMM05750G | CEBPA Antibody | 100 μl | Monoclonal Antibodies |
|
$545.00 | Add Ask |
 Leading Biology Inc.
2600 Hilltop DR, Building G, B Suite C138
Richmond, CA, 94806
Tel: 1-661-524(LBI)-0262
Email: info@leadingbiology.com
Leading Biology Inc.
2600 Hilltop DR, Building G, B Suite C138
Richmond, CA, 94806
Tel: 1-661-524(LBI)-0262
Email: info@leadingbiology.com
Complete this form and click send to ask us a question, request a quote or simply say hello.

You have 0 item in your cart

You have 0 item in your inquiry list
